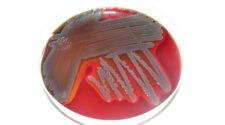
A növényvédőszerek miatt nő az antibiotikum-rezisztencia? - Tudománypláza

Új szuperbaktérium-ölő antibiotikumot fedeztek fel mesterséges intelligencia segítségével.
A mesterséges intelligencia segített leszűkíteni a több ezer potenciális vegyületet arra a maroknyira, amelyet aztán a kutatók a laboratóriumban teszteltek. Az eredmény egy erős, kísérleti antibiotikum, az abaucin. Kanadai és amerikai kutatók szerint a mesterséges intelligencia segítségével jelentősen felgyorsítható az új gyógyszerek felfedezése. Az antibiotikumok elpusztítják a baktériumokat, azonban az elmúlt évtizedekben a baktériumok egyre ellenállóbbá váltak a már létező gyógyszerekkel szemben. Becslések szerint évente több mint egymillió ember hal meg olyan fertőzésekben, amelyek ellenállnak az antibiotikumos kezelésnek. Ezért kell az új szuperbaktérium-ölő antibiotikum.
A kutatók most az egyik legproblémásabb baktériumfajra, az Acinetobacter baumanniira összpontosítottak, amely sebeket fertőzhet el és tüdőgyulladást okozhat. Ez egyike annak a három szuperbaktériumnak, amelyet az Egészségügyi Világszervezet (WHO) súlyos fenyegetésként azonosított. Az Acinetobacter baumannii több antibiotikumfajtát is képes kivédeni. Problémát jelent a kórházakban és idősotthonokban, ahol a felületeken és az orvosi berendezéseken is megél.
Rendkívüli ellenálló képessége miatt Jonathan Stokes, a McMaster Egyetem munkatársa első számú közellenségként jellemezte a baktériumot.
Ahhoz, hogy új antibiotikumot találjanak, a kutatóknak először be kellett tanítaniuk a mesterséges intelligenciát. Több ezer olyan gyógyszert vettek alapul, amelyeknek ismert volt a pontos kémiai szerkezete, és kézzel tesztelték őket az Acinetobacter baumanniin, hogy lássák, melyik képes lelassítani vagy elpusztítani azt. Ezeket az információkat aztán betáplálták a mesterséges intelligenciába, hogy az megtanulhassa a problémás baktériumot megtámadó gyógyszerek kémiai jellemzőit. Ezt követően a mesterséges intelligenciának adtak egy listát, melyen 6680 ismeretlen hatékonyságú vegyület állt. Az MI másfél óra alatt összeállította a szűkített listát, amik közül a kutatók kétszáznegyvenet vizsgáltak meg laboratóriumi körülmények között. Kilenc potenciális antibiotikumot találtak. Ezek egyike volt az abaucin, a lehetséges szuperbaktérium-ölő antibiotikum alapanyagjelölt. A következő lépés a gyógyszer laboratóriumi tökéletesítése, majd a klinikai vizsgálatok elvégzése lesz.
Érdekes módon ez a kísérleti antibiotikum nem volt hatással más baktériumfajokra az A. baumanniin kívül, holott sok antibiotikum válogatás nélkül pusztítja a baktériumokat. A kutatók úgy vélik, hogy az abaucin e tulajdonsága megnehezíti a gyógyszerrezisztencia kialakulását, és kevesebb mellékhatással járhat. A tudósok azt tervezik, hogy legközelebb a Staphylococcus aureus és a Pseudomonas aeruginosa nevű baktériumokat veszik célba.

No Comment